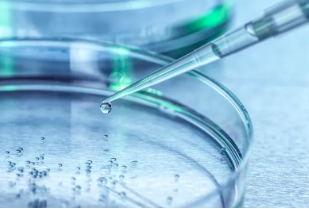
image.png

博鰲干細(xì)胞治療臨床效果有哪些優(yōu)勢與不足?如何評估其安全性?
2024-10-29 14:14:52 來源: 小編 咨詢醫(yī)生
干細(xì)胞治療作為一種前沿的生物技術(shù),近年來在全球范圍內(nèi)受到了廣泛關(guān)注。博鰲干細(xì)胞治療作為該領(lǐng)域的重要組成部分,也積累了豐富的臨床經(jīng)驗(yàn)。本文將圍繞“博鰲干細(xì)胞治療臨床效果的優(yōu)勢與不足,以及如何評估其安全性”這一主題,進(jìn)行詳細(xì)分析和探討。
一、博鰲干細(xì)胞治療臨床效果的優(yōu)勢
1.個性化治療:博鰲干細(xì)胞治療可以根據(jù)患者的具體病情,制定個性化的治療方案,提高治療效果。
2.治療范圍廣泛:博鰲干細(xì)胞治療涵蓋了多種疾病,如神經(jīng)系統(tǒng)疾病、心血管疾病、肝臟疾病等,為眾多患者帶來了希望。
3.安全性較高:博鰲干細(xì)胞治療使用的干細(xì)胞來源多樣,包括自體、同種異體等,降低了免疫排斥的風(fēng)險。
4.促進(jìn)組織修復(fù):干細(xì)胞具有強(qiáng)大的分化潛能,能夠分化為所需細(xì)胞類型,替代受損的細(xì)胞,促進(jìn)組織修復(fù)。
5.無明顯副作用:博鰲干細(xì)胞治療過程中,患者通常不會出現(xiàn)明顯的副作用,有利于患者康復(fù)。
二、博鰲干細(xì)胞治療臨床效果的不足
1.治療效果因人而異:由于個體差異,博鰲干細(xì)胞治療的效果在不同患者之間可能存在差異。
2.長期療效尚不明確:雖然博鰲干細(xì)胞治療在短期內(nèi)取得了一定的效果,但長期療效仍需進(jìn)一步觀察。
3.成本較高:博鰲干細(xì)胞治療所需設(shè)備和材料成本較高,導(dǎo)致治療費(fèi)用相對較高。
4.技術(shù)瓶頸:當(dāng)前博鰲干細(xì)胞治療技術(shù)仍存在一定瓶頸,如干細(xì)胞來源、分化調(diào)控等。
三、如何評估博鰲干細(xì)胞治療的安全性
1.嚴(yán)格篩選干細(xì)胞來源:選擇質(zhì)量合格的干細(xì)胞來源,降低免疫排斥和感染的風(fēng)險。
2.完善檢測體系:建立健全的干細(xì)胞質(zhì)量檢測體系,確保治療用干細(xì)胞的安全性。
3.加強(qiáng)臨床觀察:在治療過程中,密切觀察患者的病情變化,及時發(fā)現(xiàn)并處理不良反應(yīng)。
4.長期隨訪:對接受博鰲干細(xì)胞治療的患者進(jìn)行長期隨訪,評估治療效果和安全性。
5.多學(xué)科合作:加強(qiáng)與其他學(xué)科的交流與合作,共同探討博鰲干細(xì)胞治療的安全性問題。
總之,博鰲干細(xì)胞治療在臨床效果上具有明顯優(yōu)勢,但仍存在不足。通過嚴(yán)格評估其安全性,不斷完善技術(shù),我們有理由相信,博鰲干細(xì)胞治療將在未來為更多患者帶來福祉。
- 2024-10-11牙髓干細(xì)胞研究進(jìn)展如何?臨床應(yīng)用效果怎樣?
- 2024-11-03廣州干細(xì)胞移植手術(shù)成功率如何?
- 2024-09-09人體如何生成干細(xì)胞的,人體干細(xì)胞生成過程
- 2024-11-04中檢院認(rèn)證的干細(xì)胞公司都有哪些
- 2024-11-03干細(xì)胞技術(shù)與應(yīng)用大綱如何制定?
- 2024-10-22干細(xì)胞檢測方法有哪些新進(jìn)展?研究前景如何?
- 2024-08-09干細(xì)胞注射一次有什么效果
- 2024-09-13腎臟干細(xì)胞研究進(jìn)展,干細(xì)胞治療腎病的最新消息
- 2024-09-24鹽城干細(xì)胞作用,附上干細(xì)胞醫(yī)院名單
- 2024-10-11干細(xì)胞治療軟骨修復(fù)是否可靠?副作用有哪些?
- 2024-09-23杭州干細(xì)胞價格,杭州打干細(xì)胞多少錢一次
- 2024-07-31自體脂肪干細(xì)胞效果,自體脂肪干細(xì)胞的作用和功效
- 2024-09-02多能干細(xì)胞的作用以及應(yīng)用范圍有哪些
- 2024-08-14移植造血干細(xì)胞費(fèi)用一次多少
- 2024-08-30干細(xì)胞治療存在的問題,一文解讀干細(xì)胞療法利弊
- 2024-10-08南京牙髓干細(xì)胞作用大嗎?在臨床上有何應(yīng)用?
- 2024-09-02干細(xì)胞抗衰老應(yīng)用有哪些,應(yīng)用原理是什么
- 2024-08-22間充質(zhì)干細(xì)胞一針多少錢,能維持多久
